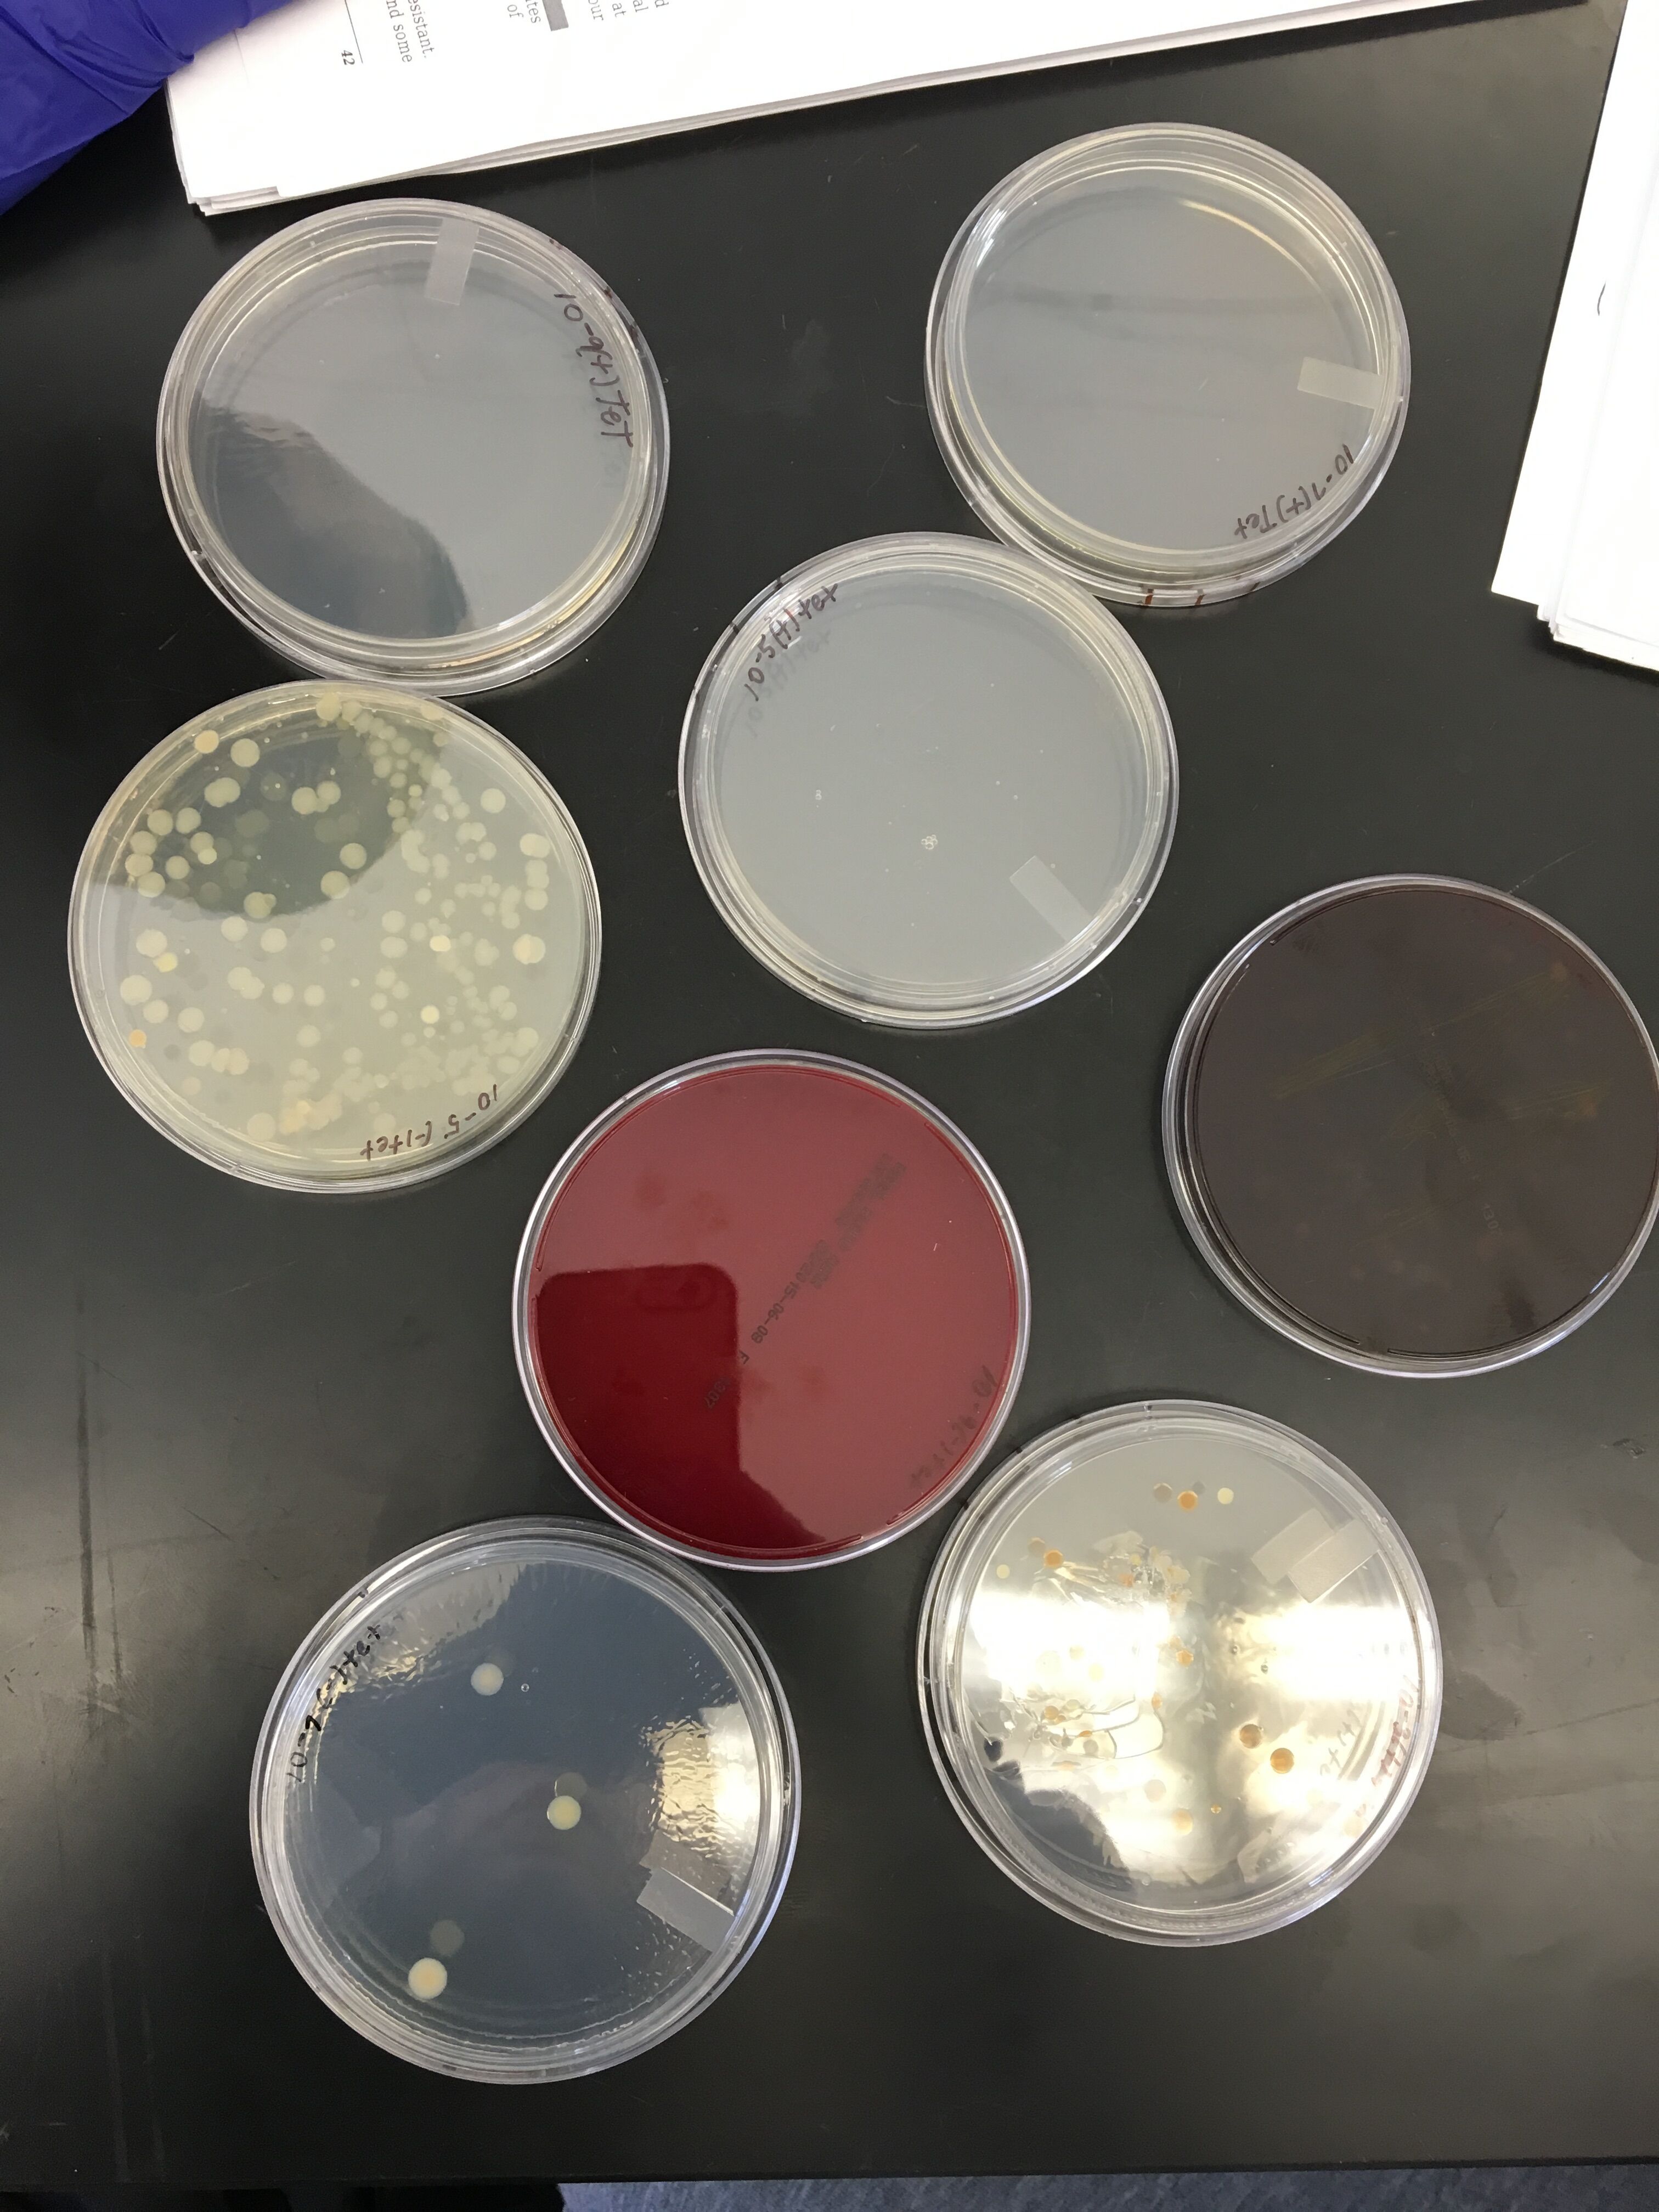

User:Sydney Anne Fry/Notebook/Biology 210 at AU
3.23.2016 Zebrafish Experiment
Purpose: The purpose of this experiment is to examine the effect of nicotine in two different dose solutions (10 g/mL and 40 g/mL) on zebrafish compared to a control group of zebrafish in normal water. If these fish are observed and maintained over the course of a couple weeks, it is predicted that the morphological conditions and the neurological responsiveness of zebrafish in the stronger dose nicotine solutions will be greatly depleted while the lower dose nicotine solution will have a minimal effect on the zebrafish.
Materials and Methods: Zebrafish were grown under three conditions: control (Deer Park water), 10 g/mL nicotine solution, 40 g/mL nicotine solution. The zebrafish were thoroughly observed at day 3, 6, 7, and 12 of their life cycle and detailed size, shape and movement notes were taken at the designated days. Use a dropper to place 24 healthy and translucent embryos into separate dishes being careful to minimize the amount of water deposited in the wells along with the zebrafish.
Data and Observations:
Day 3:
Observing the zebrafish after 3 days of the experiment led to the results that none of the control solution zebrafish have hatched. All the control embryos seemed to be at the 4-somite stage. Zebrafish in the 10 g/mL nicotine solution grew quicker than the control zebrafish and 6 of the 8 zebrafish had hatched by day 3. Like the 10 g/mL nicotine solution, the zebrafish in the 40 g/mL nicotine solution grew faster than the control. These zebrafish had both embryos and hatched fish. Two of these zebrafish were already dead.
Day 6:
Day 6 of the experiment shed a lot of light on the zebrafish and their development while being exposed by nicotine solutions. Zebrafish in all three solutions (control, 10 g/mL nicotine, 40 g/mL nicotine) were examined. One fish from each solution was selected for measurement of body length and eye size. A total of 5 zebrafish (1 from 10 g/mL solution; 4 form 40 g/mL solution) had died. The movement and stimuli of all of the other fish were then tested and recorded. Patterns found were that the stimuli response of the zebrafish varied with the solution they were in. Most of the zebrafish in control solution had normal and quick responses to tapping or shaking the dish along with constant movement. Differing from the control, the solutions with 10 g/mL and 40 g/mL nicotine contained zebrafish with limited movement and delayed responses. More so in the higher concentration nicotine solution, the zebrafish either did not move or were dead. Another pattern noticed is that the body length of the zebrafish in the 10 g/mL and 40g/mL nicotine solution were much smaller (20 os) compared to the control zebrafish (34 os).
Day 7:
The experiment led to results on day 7 to be similar to the results found on day 6. Two zebrafish, one from the control solution and one from the 10 g/mL solution were taken for preservation. A total of 9 (2 from 10 g/mL nicotine solution; 7 from 40 g/mL nicotine solution) were dead. That leaves one zebrafish left alive in the 40 g/mL nicotine solution. The zebrafish in the 40 g/mL nicotine solution that was still alive had a very deformed and bent body. Patterns found on day 7 are similar to day 6 in the sense that the body length of the control zebrafish (40 os) was longer than the body length of the 10 g/mL zebrafish (30 os).
Day 12:
Results for day 12 of the experiment are very short. All of the zebrafish except one have died. This zebrafish was in well column 4, row 4 and was exposed to 10 g/mL nicotine solution. The fish had very large eyes and a bent body but seemed to be mobile with good responses.

Conclusion:
After the experiment had been finished the final conclusions had been made about nicotine exposure to developing zebrafish:
Nicotine solutions stunt body length growth of zebrafish Nicotine solutions affect eye size of zebrafish (makes them larger) Nicotine diminishes zebrafish movement and response to stimuli Nicotine causes the body shape of the zebrafish to be morphed Nicotine is fatal to zebrafish The greater the concentration of the nicotine solution, the more negatives effects are enhanced
3.16.2016 Vertebrates and Niches
Purpose: The purpose of this procedure in the lab notebook is to consider vertebrates that would pass through the small transect on a daily basis. The consideration of these invertebrates is important because the size of the animals causes the inability to observe them in a laboratory atmosphere.
Materials and Methods: Looks at the different vertebrates in the Freeman textbook and identify possible vertebrates that would live in the transect; classify them. Consider the biotic and abiotic characteristics of the transect and how they would benefit each species. Construct a food web from looking at how to do so in the textbook and include all organisms considered in the transect.
Data and Observations:
There are an abundance of vertebrates that could inhabit transect two throughout the course of the day. Here are some examples of vertebrates that could cross through the transect at any given time:
1. Mammalia; squirrels 2. Reptilia; lepidosauria; lizards 3. Aves; birds; sparrows 4. Aves; birds; cardinals 5. Mammalia; rats
Numerous biotic and abiotic features benefit each species identified in the transect; thus the reasons for them occupying this space.
For squirrels, an abiotic factor that can benefit them is the dirt in the transect; it gives them a place to burry and store their food. Leaves and trees are a biotic factor that give squirrels oxygen to breathe to keep them living. Trees also give squirrels a place to climb away from the ground to protect them from predators.
An abiotic factor that would benefit lizards in the transects are any rocks that can be warmed by the sun that the lizards lay on to keep their body temperature up since they are cold blooded. Lizards can count on the biotic factor of bugs to keep them energized through ingestion.
Both birds, sparrows and cardinals, benefit the abiotic factor of water in the transect to keep them hydrated. Trees are a biotic factor necessary for birds so they can seek shelter above the ground. Another biotic factor that birds can benefit from are the worms in the ground and the bugs that they eat for energy. Straw from the ground is an abiotic factor that the birds can use to make nests for their offspring.
Rats benefit from the abiotic factor of water to hydrate them while the use of the biotic factor of bushes give shelter to rats and a place for them to hide from predators. The abiotic factor of scraps/trash also benefits the rats as a food source.
Food Web:
Figure 1. Above is a food web describing possible vertebrates in transect two.
The term community refers to a group of different populations living in the same geographical area. Because so many different species were identified through this experiment, it can be deduced that transect two is a community. Transect two is a very small piece of ground which brings up the question of carry capacity. The limiting space of the transect only allows a small number of different species to live in the area at a time; obviously the vertebrates because of their size are more limited to the number of individuals than bacteria or invertebrates. The vertebrates identified in the lab are members of the higher level trophic levels because they consume the lower trophic levels and need their energy to sustain their larger size.
Conclusions:
Transect two consists of all different types of vertebrates that interact with biotic and abiotic factors including the organisms we have observed prior to this notebook entry.
3.4.2016 PCR Identification
Purpose: The purpose of the notebook entry is to understand how gene sequencing can be used to identify specific species of bacteria.
Methods and Materials: Find a old gene sequence from transect two from past years labs and go to http://blast.ncbi.nlm.nih.gov/Blast.cgi to blast the bacteria.
Data and Observations:
AGTCGAGCGCCCCGCAGGNNAGCGGCAGACGGGTGAGTAACGCGTGGGAACGTACCT TTTGCTACGGAATAACTCAGGGAAACTTGTGCTAATACCGTAGGTGCCCTTCGGGGGAAAGATTTATCGGCAAAGGATCG GCCCGCGTTGGATTAGCTAGTTGGTGAGGTAAAGGCTCACCAAGGCGACTATCCATAGCTGGGCTGAGAGGATGATCAAC CACACTGGGACTGAAACACGGCCCANACTCCTACGGGAGGCAGCAGTGGGGAATATTGGACAATGGGCGCAAGCCTGATC CATCCATGCCGCGTGAGTGATGAAGGCCCTAGGGTTGTAAAGCTCTTTCACCGGTGAAGATAATGACGGTAACCGGAGAA CAAGCCCCGGCTAACTTCGTGCCAACAGCCGCGGTAATACGAAGGGGGCTAACGTTGTTCGGATTTACTGGGCGTAAAGC GCACGTAGGCGGACTTTTAAGTCAGGGGTGAAATCCCGGGGCTCAACCCCGGAACTGCCTTTGATACTGGAAGTCTTGAG TATGGTANAGGTGAGTGGAATTCCGAGTGTANAGGTGAAATTCNTANATATTCNGAGGAACACCAGTGNNGAANGCGGCT CACTGGACCATTACTGACGCTGANGTGCNAAAGCGTGGGGAGCAAACANGATTANATACCCTGGTAGTCCACGCCGTANA CGATGAATGTTAGCCGTTGGGGAGTTTACTCTTCGGTGGCGCAGCTAACGCATTAAACATTCCGCCTGGNGAGTACNGTC GCAAGATTAAAACTCANANGAATTGACNGGGGCCCGCACAAGCGGTGGAGCATGTGGTTTAATTCNAANCAACGCNCAAA CCTTACCANCCCTTGACATACCGGTCGCGGACACAGANATGTGTCTTTCANTTCNNCTGGACCGGATACANGTGCTGCAT GGCTGTCNTCANCTCGTGTCNNGAGATGTTGNGTTAAGTCCCNGCAACGANCGCAACCCCTCNNCCTTANTTGCCAGNNT TTANNTGGNCACTCTA
Figure 1.1 Image of ochrobactrum species.
Conclusions:
After blasting the gene sequence there was a 100% match with the ochrobactrum species. This species of bacteria are gram-negative that are small robs with one end flame shaped. They are a type of proteobacteria. Because our lab group's gene sequencing failed, we sequenced a similar bacteria from the same transect. This bacteria could be the same bacteria we found because it is small and rod shaped similar to bacteria we found.
2.22.2106
Identifying Invertebrates and Vertebrates
Purpose: The purpose of this lab is to be able to identify invertebrates from transect two using a dichotomous key (especially arthropods) as well as understanding aspects of invertebrates and vertebrates such as: the different germ tissues, mechanisms of motility, differences between acoelomates, psuedocoelomates, and coelomates, symmetry of an animal and the difference between protosomes and deuterosomes.
Methods and Materials: Observe the different kinds of dissecting tracts of organisms under a microscope and note the differences. Observe and classify organisms from the five major classes.
Carefully breakdown the Berlese Funnel and pour the top of 50% ethanol and organisms into a petri dish and then pour the remaining liquid into a second dish. Examine both under a microscope. Identify the class of any Arthropoda invertebrates you observe; at least five invertebrates. Use the dichotomous key to identify the name. Measure each organism.
Data and Observations:
Table 1.1 Identification table of first four organisms found in Berlese Funnel collections.
The other organism identified was also in the phylum arthropoda and the smallest of all the organisms coming in at half a millimeter. It was round black and beetle shaped.
Image 1.1 Organism two from Table 1.1
Image 1.2 Organism four from Table 1.1
Image 1.3 Organism one from Table 1.1
Image 1.4 Picture of petridish containing the bottom part of the Berlese Funnel sample
Image 1.5 Organism three from Table 1.1. Correction from the table, this organism is in phylum Arachnida because of the eight legs and is a spider.
Image 1.6 Picture of organisms in the Berlese Funnel
Image 1.7 Organism number five found and identified
Image 2.1 Possible food web for transect two.
Conclusion:
To conclude the Berlese Funnel, the organisms found were all from the phylum arthropoda and ranged between .5 millimeters to .5 centimeters. The spider like invertebrate was the largest and the beetle like invertebrate was the smallest. Because arthropoda were the majority type of organisms found, it can be concluded that this is the most common organism in leaf litters. The different samples of the Berlese Funnel were not different enough to give indication that the top and bottom consisted of different habitats.
2.15.2016 Identifying and Studying Plants and Appreciating Fungi
Purpose: The purpose of this lab is to go to transect two, take samples of various plants from around the transect, take them back into the lab and identify and differentiate the types of plants. Along with this, to appreciate fungi, observing slides of different fungi under a microscope gives one a better understanding of fungi.
Methods and Materials: Obtain three ziploc bags and go to transect two. Obtain a leaf litter sample to set up the Berlese funnel for collecting invertebrates for next week's lab. Take samples from five different plants in the transect. Observe the moss and its height and compare it to the height of a lily plant. Examine the cross section of a lily stem. From the set up slides, observe to see the presence of specialized structures and mechanisms of plant reproduction.
To set up the Berlese funnel pour 25 mL of the 50:50 ethanol/water solution in the 50mL conical tube. Put a piece of screen on the bottom of the funnel and put the leaf litter into the top of the funnel. Parafilm the base of the funnel so the ethanol will not evaporate. Place a lamp above the funnel and cover everything with foil.
Data and Observations:
The first plant we obtained from the transect is a leaf from the thin, small tree near the front of the transect. The leaves from the trees are small and oval shaped. From the back left corner of the transect, we took a few branches of the fern on the ground. The fern was a long stem with a ton of small oval leaves stacked on either side of the stem. We took ivy leaves from the right side of the transect. The ivy leaf is dark green with multiple points on the leaf. There were long strands of grass from the left side of the transect we obtained. The strands of grass were long and thin. The last plant we took from the transect was a branch of leaves from a bush in the front/middle of the transect. These leaves were yellowish green and were in bunches on the branch of the bush.
Figure 1.1 Picture of fern from transect.
Figure 1.2 Picture of grass from transect.
Figure 1.3 Picture of leaf from tree from transect.
Figure 1.4 Picture of ivy leaf from transect.
Figure 1.5 Picture of bush leaves from transect.
Figure 2.1 Dissecting scope picture of fern.
Figure 2.2 Dissecting scope picture of tree leaf.
Figure 2.3 Dissecting scope picture of bush leaf.
Figure 2.4 Dissecting scope picture of ivy leaf.
Figure 2.5 Dissecting scope picture of spores on underneath side of fern leaf.
Figure 3.1 Characterization of plants collected from the transect.
Figure 3.2 Characterization of plants collected from the transect.
The fungi sporangia are structures that hold spores which are released when the sporangia opesn. This is important in fungi because it is one of their methods of reproduction.
Figure 4.1 Microscope picture of fungus. This is fungus because it has hyphae/mycelium.
Conclusion: This lab allowed me to understand the differences in plants and whether they are monocot/dicot, angiosperm/gymnosperm, and whether they have stomata or not. Looking at fungus under a microscope gave me a better understanding of the structure of fungus and why they are different than plants. Seeing how many different types in a small transect allows for a better understanding of the vast diversification of plants in the environment.
2.9.2016 Identifying and Studying Bacteria
Purpose: The purpose of this lab is to take the serial dilutions of the hay infusion from last week and observe the bacteria colonies that have grown on the agar plates. Using a microscope, the bacteria from the agar plates were observed and a gram stain was done to look at the bacteria under color as well.
Methods and Materials: Observe the bacteria colonies on the agar plates. Make a wet mount of bacteria from the nutrient agar plates and one from the nutrient plus tetracycline agar plates; determine whether the organism is motile and its shape.
From the same colony samples as the wet mount, make a gram stain for each. To do this, mix your bacteria sample with a drop of water on a slide; heat over a flame three times. Cover the bacteria smear with crystal violet for one minute; rinse with water. Cover bacterial smear with iodide mordant for 1 minute; rinse with water. Decolorize with 95% alcohol for 10-20 seconds; rinse gently. Cover smear with safranin stain 20-30 seconds; rinse. Do not use a cover slip for a gram stain.
Set PCR amplification up using the bacteria from one nutrient agar plate and one nutrient agar plate with tetracycline. Label 2 CPR tubes and add twenty microliters of primer/water mixture to the PCR tube and mix to dissolve the PCR bead. Submerge toothpick into the mixture and twist for five seconds. Use clean toothpick for each colony. Cap tube and place in PCR machine.
Data and Observations:
Figure 1.1 Bacteria on nutrient agar plates and nutrient tet + agar plates
In the agar plates with tetracycline added to it there were less number of bacteria colonies than in the normal nutrient agar plates. The colonies in the tet + plates were extremely larger than the latter which indicates that certain bacteria types in the nutrient plates were killed with the tetracycline allowing the bacteria that survived the antibiotic to grow larger. Tetracycline attacks the ribosomes in bacteria and the types of bacteria that are sensitive to this antibiotic will die.
Table 1.1 Bacteria characterization table
The two bacteria observed from the nutrient agar plates ended up being coccus shaped and immobile. They were taken from colonies with a 10^-5 and 10^-9 (see figure 1.7) serial dilutions. From the 10^-7 and 10^-9 serial dilutions from the agar plates with tetracycline were observed and both of the bacteria were bacillus shaped and non motile (see figures 1.5 and 1.6).
Table 1.2 Serial dilutions table
Figure 1.2 Gram stain of coccus bacteria
Figure 1.3 Gram stain of bacteria
Figure 1.4 Gram stain of bacteria
Figure 1.5 Bacillus bacteria from agar plate tet + 10^-7
Figure 1.6 Bacillus bacteria from agar plate tet + 10^-9
Figure 1.7 Coccus bacteria from agar nutrient plate 10^-9
Conclusion:
This experiment let me observe and understand the different shapes and forms bacteria in my transect have and how to make a gram stain. Serial dilutions and the use of tetracycline allowed me to realize the affects of antibiotics on bacteria and whether or not certain bacterias are resistant to tetracycline or not. Because both of the colonies taken from the tet + agar plates both have the bacillus form I conclude that the bacillus bacteria is more likely to survive antibiotics than the coccus shape of bacteria.
SAF
2.3.2016 Identifying Algae and Protists from Hay Culture Infusion
Purpose: The purpose of this lab is to be able to use a dichotomous key to identify organisms in the hay infusion culture that was made from last week and understanding the defining characteristics of protists and algae. Through microscopes, the dichotomous key will be used to identify the organisms through noticing their size, color, shape, mobility, etc. If we observe a wet mount slide under a microscope then an abundance of protists will be seen.
Materials and Methods: Make a wet mount of known organisms and observe under the microscope at 4x, 10x, and maybe 40x whether the organism is immobile or not. Use a dichotomous key to determine the identity of the organisms found. Record description and use dichotomous key to identify them.
Data and Observations:
Hay Infusion Description: The hay culture after one week seems to have about an inch of water evaporated. Differing from last week, the film on the top, which seems to be a mold, is a lot thicker. It has turned into a opaque white/grey color. There were no green shoots on the top of the culture. All the sediment that was floating around in the culture from last week has fell tot he bottom and is a layer of brown about half a centimeter thick. The leaves in the culture are more broken down and wilted. The smell is stronger than last week but still smells like rotting food and dirt.
 Figure 1. Picture of hay infusion culture after two weeks for transect two.
Figure 1. Picture of hay infusion culture after two weeks for transect two.
Niche Sample: Our lab group took culture samples from the top, middle and bottom of the culture. The slides from the top and middle of the culture did not indicate any protists. But when looking at the bottom culture slide; our group found an abundance of protists.
Under the microscope, the protists were moving so quickly it was hard to identify them under 40x magnification. Three different protists were identified; all were motile though they varied in speed. None were green thus we concluded none of the protists found were photosynthesizing. The first protist we found was chlamydomonas, it was about 5 micrometers in length and roundish. The next protist we identified was a paramecium. There were many different sizes of paramecium in our slide indicating the existence of numerous species of paramecium, but the one that was measured was only 2.5 micrometers. It was long and oval shaped and moved very quickly. The last protist was a chilomonas, about 75 micrometers in length. These reminded me of little space ships and moved using two flagella on the back on the organism; the front was pointed.

 Figure 3. Sketches of protists found in hay infusion culture.
Figure 3. Sketches of protists found in hay infusion culture.
 Figure 4. Photo of protists at 10x magnification.
Figure 4. Photo of protists at 10x magnification.
 Figure 5. Microscope photo of chlamydomonas at 40x magnification.
Figure 5. Microscope photo of chlamydomonas at 40x magnification.
 Figure 6. Photo of paramecium at 10x magnification
Figure 6. Photo of paramecium at 10x magnification
Conclusions and Future Directions:
The chilomonas meets all the needs of life because…. 1.it has energy, it is moving so energy is required for this 2.it is an organism made of cells 3.the nucleus is visible inside of this protist so it is deduced that it has information 4.because it is a prokaryotes, it reproduces through asexual reproduction 5.prokaryotes are ancient organisms so the fact that the chilomonas is still around means that it is constantly evolving.
If the Hay Infusion culture grew for another two months I would expect a lot more mold to reproduce. But the fact that there is limited plant matter and space in the culture, I would predict that much of the organic matter would decompose because of the organisms present in the culture. I question that since the culture is small will there ever come a time where organisms such as protist have no more room to reproduce and grow and eventually everything will become dead matter?
This experiment produced a various amount of species of protists and allowed me to get to see what living protists looked like underneath a microscope. The dichotomous seemed to be simple to use but once the protists were under the microscope and moving quickly I found it a lot more difficult to identify them. This experiment was more about gaining a better understanding on protists and archaea therefore, I cannot necessarily reject or accept a hypothesis other than saying I got a better understanding of the life living inside of the hay culture.
SAF
1/26/2016 Transect Description
Abiotic components of transect: 1. rocks 2. soil 3. water 4. brick 5. irrigation system
Biotic components of transect: 1. trees 2. ferns 3. worms 4. grass 5. squirrel
Description of transect 2: Transect 2 was located adjacent to the amphitheater on American's campus. The transect's main component was a small creek running through the middle of it. Water was running through the stream with sediment, rocks, and pebbles lining the bottom; a few large branches laid inside the creek. There were many large boulders throughout the transect and only a handful of trees. On the right side of the transect was a lot of ivy and a large amount of bushes line the back wall of the transect. At the front of the transect was a plastic irrigation system plate and a walkway of rocks to the creek. The soil throughout the transect was rather dry, rocky and filled with stones. There was a brick that was thrown in the creek.
SAF